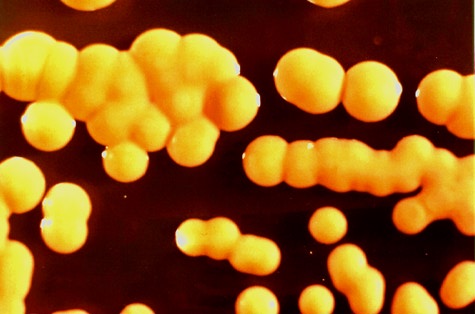
Los cocos son bacterias redondeadas

| |
LA
CÉLULA BACTERIANA
|
Las bacterias son células muy
sencillas; carecen de núcleo y tampoco
presentan orgánulos en el citoplasma. Se las
denomina Procariotas. Son organismos
unicelulares y se encuentran en todos los
ecosistemas.
Las bacterias son un numeroso
grupo de seres vivos, con características
muy diversas. En la clasificación de los
Dominios, Woese, aparecen dos grupos de
Procariotas, el Dominio Archaea, que
engloba a los organismos más antiguos del
Planeta, y el Dominio Bacteria, en el
que se encuentran la gran mayoría de los
organismos bacterianos actuales, también
conocidos con el nombre de Eubacterias.
Las formas que presentan las
bacterias pueden ser:
|
Coco |
Bacilo |
Vibrión |
Espirilo |
|
 |
 |
 |
Las bacterias pueden
presentarse como individuos sueltos,
o formando colonias. Se pueden
encontrar colonias de diplococos
(bacterias redondeadas, de dos en dos),
diplobacilos (bacterias alargadas, de
dos en dos), estreptococos (cordones
de bacterias redondeadas), estafilococos
(masas laminares de bacterias
redondeadas) o sarcinas
(conglomerados tridimensonales de bacterias
redondeadas).
Estructura bacteriana
De fuera hacia dentro de la
bacteria encontramos los siguientes
componentes:
|
|
Este componente no aparece en
todas las bacterias. Está formada por
polímeros glucídicos que no llegan a
formar una estructura definida. Esta cápsula
es capaz de retener agua, con lo que actúa
como reservorio de agua. También
sirve de sustrato para los
desplazamientos de las células que la
poseen, pues éstas no disponen de flagelos.
Sirve además como matriz adherente
entre las bacterias, sin llegar a formar una
auténtica colonia. Impide la acción
fagocítica de otras células dificultando el
reconocimiento de la bacteria, por lo que
también cumple una función defensiva.
|
|
 |
|
Estructura rígida y
resistente que aparece en la mayoría de las
células bacterianas. La pared bacteriana se
puede reconocer mediante la tinción Gram,
que permite distinguir dos tipos de paredes
bacterianas:
La función de la pared
bacteriana consiste en impedir el estallido
de la célula por la entrada masiva de agua.
Éste es uno de los mecanismos de actuación
de los antibióticos; crean poros en las
paredes bacterianas, provocando la turgencia
en la bacteria hasta conseguir que estalle.
Ampliación de contenidos: pared celular
|
|
 |
|
Envoltura que rodea al
citoplasma. Está formada por una bicapa de
fosfolípidos. No contiene colesterol. La bicapa lipídica está atravesada por gran
cantidad de proteínas (80%), relacionadas con las
distintas actividades celulares.
En la membrana aparecen
grandes repliegues, denominados mesosomas.
Estos mesosomas realizan varias funciones,
tales como servir de anclaje para el ADN
bacteriano, intervenir en la división
celular (bipartición), o ser el lugar
donde se realiza parte de la respiración
celular en las bacterias aerobias. También
se encuentran las moléculas necesarias para
realizar la fotosíntesis en bacterias
fotosintéticas.
|
|
 |
|
Es el espacio que
se encuentra dentro de la membrana plasmática.
Contiene inclusiones cristalinas, sustancias de
reserva, gotas lipídicas, enzimas y otras
proteínas.
Se encuentran
ribosomas 70s
y una región densa,
donde se encuentra el ADN bacteriano;
esta región no se encuentra separada del resto del
citoplasma por ninguna membrana. El ADN bacteriano
es ADN bicatenario, circular.
Algunas bacterias
presentan ADN extracromosómico. Este ADN se
denomina plásmido.
Los plásmidos están relacionados con la
resistencia a antibióticos
u otras sustancias
tóxicas para la célula. También son necesarios
para unir la bacteria a una superficie, ya sea a
una macromolécula alimenticia, a un líquido, o a
otra célula para realizar un tipo concreto de
reproducción, denominada conjugación.
Para poder realizar esta conjugación, el plásmido
debe contener información para la formación de
pili.
Algunas bacterias
presentan
flagelos.
Estos flagelos atraviesan la pared celular y
permiten el desplazamiento de la bacteria. También
pueden encontrarse
pili.
Algunas bacterias
son capaces de formar estructuras de resistencia,
llamadas endosporas,
cuando aparecen condiciones adversas en el medio
en el que vive.
|

|